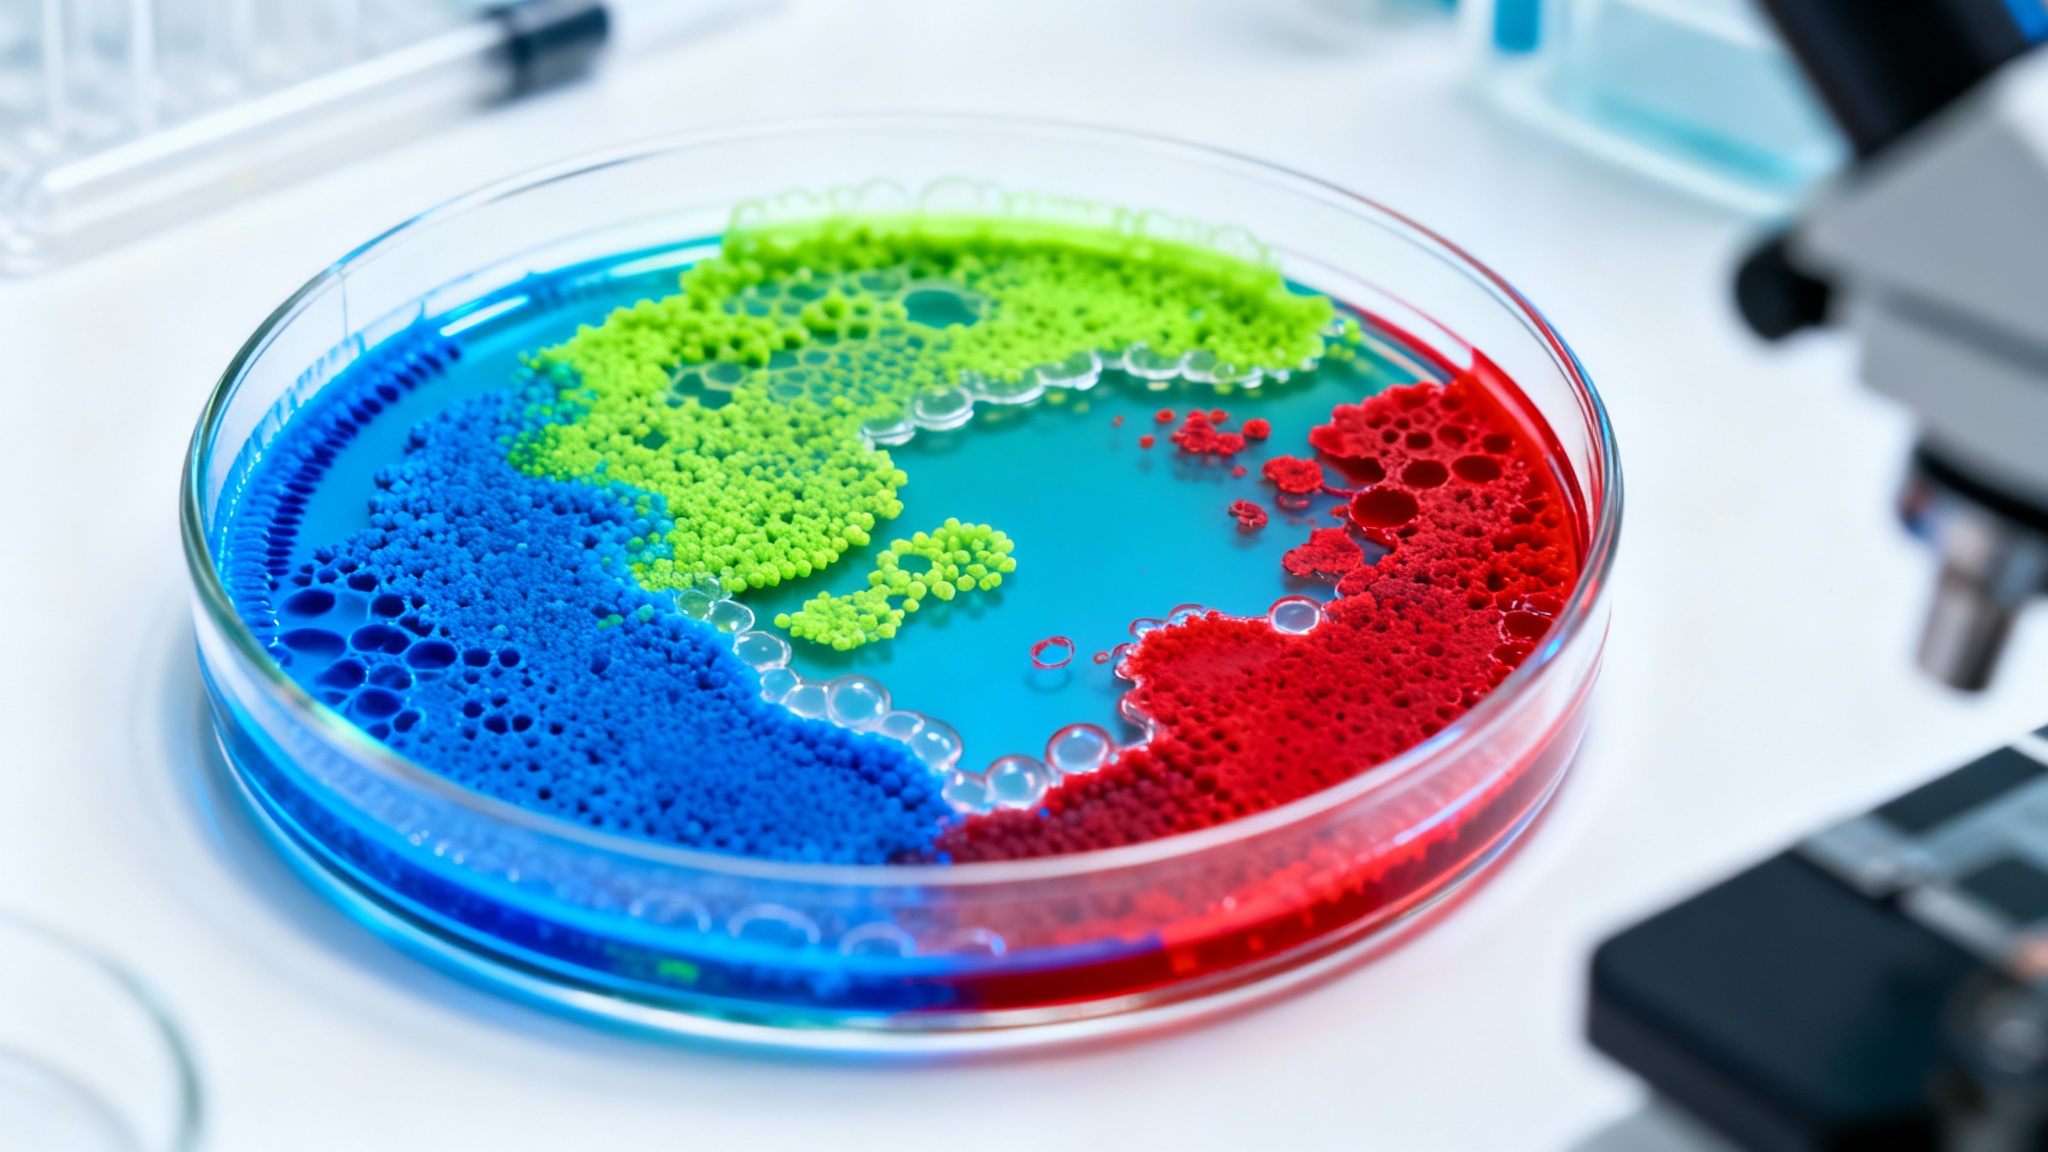

Quels sont les microbes intestinaux qui comptent vraiment ? Une étude majeure classe les bactéries selon leur impact
Auteur: Mathieu Gagnon
Le microbiote, cette nouvelle star de la santé

Depuis quelques années, on ne parle que de lui, ou presque. Le microbiote intestinal est devenu une sorte de célébrité dans le monde de la science médicale, captivant aussi bien les chercheurs pointus que le grand public. Pourquoi un tel engouement ? Eh bien, c’est surtout à cause de son lien direct avec notre santé générale et certaines maladies chroniques comme le diabète de type 2 ou les maladies cardiaques. C’est fascinant de se dire que c’est un élément de notre santé que l’on peut, en théorie, modifier.
Pourtant, il faut rester humble… la science qui entoure ce monde microscopique est encore en plein développement, et nous avons énormément de choses à apprendre. C’est là qu’intervient une nouvelle étude, tout juste publiée dans la prestigieuse revue Nature, qui vient d’ajouter une pierre considérable à l’édifice de notre compréhension du microbiome humain.
Une analyse massive sur plus de 34 500 personnes

L’équipe de recherche n’a pas fait les choses à moitié, c’est le moins qu’on puisse dire. Ils ont analysé le microbiote intestinal, l’alimentation et divers marqueurs de santé de plus de 34 500 personnes réparties entre les États-Unis et le Royaume-Uni. C’est une quantité de données assez vertigineuse quand on y pense. Grâce à cela, ils ont pu relier des centaines d’espèces spécifiques de microbes intestinaux à des indicateurs clés de notre santé et de notre régime alimentaire.
Ces données proviennent du programme Zoe PREDICT, mené au Royaume-Uni et aux États-Unis par l’entreprise de tests de microbiome Zoe. C’est grâce à cette base de données immense que les chercheurs ont pu aller aussi loin dans l’analyse, en dépassant les simples observations anecdotiques pour trouver des tendances lourdes.
Un nouveau système de classement par apprentissage automatique

Pour traiter cette montagne d’informations, les chercheurs ont fait appel à l’apprentissage automatique, ou machine learning. Ils ont examiné précisément 34 694 participants pour associer certaines espèces microbiennes à l’alimentation et à des facteurs de risque courants. On parle ici de l’IMC (Indice de Masse Corporelle), des triglycérides, de la glycémie et de l’HbA1c, ainsi que d’autres marqueurs cliniques intermédiaires de la santé cardiométabolique.
Sur un total de 661 espèces microbiennes non rares identifiées, l’équipe a décidé de se concentrer sur les extrêmes pour y voir plus clair : les 50 espèces les plus favorablement associées à une bonne santé, et, à l’inverse, les 50 espèces les plus défavorablement liées à notre bien-être. C’est un travail de tri colossal, un peu comme chercher des aiguilles spécifiques dans une botte de foin biologique.
Le classement ZOE 2025 : noter nos bactéries

Ce processus rigoureux a abouti à la création de ce qu’ils ont appelé le « ZOE Microbiome Health Ranking 2025 » et le « Diet Ranking 2025 ». Le principe est assez simple à comprendre : c’est une échelle utilisée pour noter les microbes comme étant soit bénéfiques, soit néfastes pour la santé, sur une échelle allant de 0 à 1. C’est un peu comme un bulletin scolaire pour nos bactéries.
Dans ce système, les microbes dont le score est plus proche de zéro sont considérés comme positivement corrélés aux marqueurs de santé, tandis que ceux qui se rapprochent de un sont corrélés négativement. Cette notation a été appliquée scrupuleusement pour l’ensemble des 661 microbes étudiés. Le crédit de cette publication revient à Nature (2025), avec le DOI suivant pour les curieux : 10.1038/s41586-025-09854-7.
Lien entre bactéries, obésité et maladies

Ce système de classement a permis d’identifier des centaines d’espèces de microbes intestinaux — décrites dans l’article comme des bacs génomiques au niveau de l’espèce (SGB) — qui sont significativement associées à la qualité de l’alimentation et à la santé. Sans surprise, ou peut-être que si, ils ont constaté que les microbes « favorables » étaient plus fréquents chez les personnes ayant un IMC plus bas et moins de maladies, alors que les microbes « défavorables » prospéraient chez ceux souffrant d’obésité.
Une partie spécifique de l’étude s’est penchée sur l’IMC en utilisant les données de 5 348 individus en bonne santé. Ces participants ont été divisés en trois catégories classiques : poids santé, surpoids et obésité. Cela a permis de comparer directement la flore intestinale en fonction de la corpulence, sans le bruit de fond d’autres pathologies graves.
Des chiffres parlants : 5,2 espèces de différence
Les résultats sont assez frappants quand on regarde les chiffres. L’équipe d’étude écrit que la méta-analyse, basée sur une régression linéaire, a montré que les individus ayant un poids santé portaient, en moyenne, 5,2 espèces de plus parmi les 50 SGB classés favorablement par ZOE que les personnes souffrant d’obésité. C’est une différence biologique notable, pas juste une variation statistique mineure.
L’équipe a également cherché à savoir si ces SGB bien classés étaient plus abondants chez les participants ayant une maladie définie. Et effectivement… les gens du groupe témoin (sans maladie) avaient des niveaux plus élevés de microbes intestinaux favorables que les personnes malades. À l’inverse, ceux avec des maladies hébergeaient davantage de microbes mal classés. C’est une confirmation assez claire du lien entre la flore et l’état pathologique.
L’impact de l’alimentation : études ZOE METHOD et BIOME

Mais alors, peut-on changer la donne en mangeant mieux ? Il semble que oui. Les interventions diététiques ont permis d’augmenter les microbes favorables et de réduire les indésirables. L’équipe a analysé les données de deux études distinctes, appelées ZOE METHOD et BIOME. Dans ces essais, les participants suivaient soit un programme d’intervention diététique personnalisé (PDP) conçu pour améliorer le microbiome, soit prenaient un supplément prébiotique.
Les microbiomes de ces participants ont changé de manière significative à la fin des études, ce qui est une excellente nouvelle. Comme l’expliquent les auteurs, les groupes d’intervention diététique des deux essais cliniques (mélange prébiotique pour BIOME et PDP pour METHOD) ont montré le plus grand nombre de SGB changeant de manière significative. Cela prouve que notre flore n’est pas une fatalité figée.
Les bactéries spécifiques qui changent la donne

En se concentrant sur les microbes intestinaux les plus significatifs ayant subi le plus grand changement relatif après ces interventions, les chercheurs ont fait des trouvailles précises. Ils ont constaté une augmentation de Bifidobacterium animalis — une bactérie présente dans les aliments à base de produits laitiers et chez les gens qui en consomment beaucoup. Mais ce n’est pas tout, loin de là.
Ils ont aussi noté l’augmentation d’une bactérie inconnue de la famille des Lachnospiraceae et de R. hominis, toutes deux précédemment associées à un régime végétalien. Une autre bactérie inconnue des Lachnospiraceae, liée cette fois à un régime végétarien, a aussi été repérée. C’est fascinant de voir comment des choix alimentaires spécifiques invitent des hôtes microscopiques particuliers à notre table intérieure.
Vers une meilleure compréhension

Au-delà de relier des espèces bactériennes connues à la santé, l’équipe a aussi découvert de nombreux microbes clés associés à la santé qui étaient jusqu’alors des espèces non caractérisées. Je trouve ça incroyable… imaginer que des organismes vivant en nous restent encore mystérieux ! Les études futures pourront potentiellement décrire ces nouvelles espèces plus en détail.
Bien sûr, il faut garder à l’esprit qu’il s’agit d’une étude observationnelle. Elle ne peut pas prouver définitivement la causalité — c’est-à-dire que le microbe cause la bonne santé ou l’inverse. Cependant, ces nouveaux classements peuvent guider les recherches futures sur les liens de cause à effet, et surtout inclure des populations plus diverses et des interventions directes pour confirmer tout cela.
Ce contenu a été créé avec l’aide de l’IA.